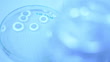

Bacteria Culture - HD stock video
Dolly shot video of Bacteria Culture In a Petri Dish (HD)

PURCHASE A LICENSE
All Royalty-Free licenses include global use rights, comprehensive protection, simple pricing with volume discounts available
€475.00
EUR
DETAILS
Credit:
51³Ô¹ÏÍø #:
163870084
License type:
Collection:
Creatas Video
Max file size:
1920 x 1080 px - 247 MB
Clip length:
00:00:12:21
Upload date:
Release info:
No release required
Mastered to:
QuickTime 10-bit ProRes 422 (HQ) HD 1920x1080 23.98p
Categories:
- Cryobiology,
- Laboratory,
- 10 Seconds or Greater,
- Agar Jelly,
- Analyzing,
- Bacterium,
- Biochemistry,
- Biology,
- Biotechnology,
- Chemical,
- Chemical Reaction,
- Chemistry,
- Cladosporium,
- Close-up,
- Color Image,
- Discovery,
- E. coli,
- Enterobacteria,
- Equipment,
- Film - Moving Image,
- Fungal Mold,
- Glass - Material,
- HD Format,
- Healthcare And Medicine,
- Horizontal,
- Indoors,
- Laboratory Glassware,
- Medical Equipment,
- Medical Research,
- Medicine,
- Micro Organism,
- Microbiology,
- No People,
- Non US Film Location,
- Panning,
- Petri Dish,
- Poisonous,
- Progressive Scan,
- Real Time Video,
- Research,
- Satratoxin,
- Science,
- Science and Technology,
- Scientific Experiment,
- Selective Focus,
- Specimen Holder,
- Toxic Mold,
- Toxicology,